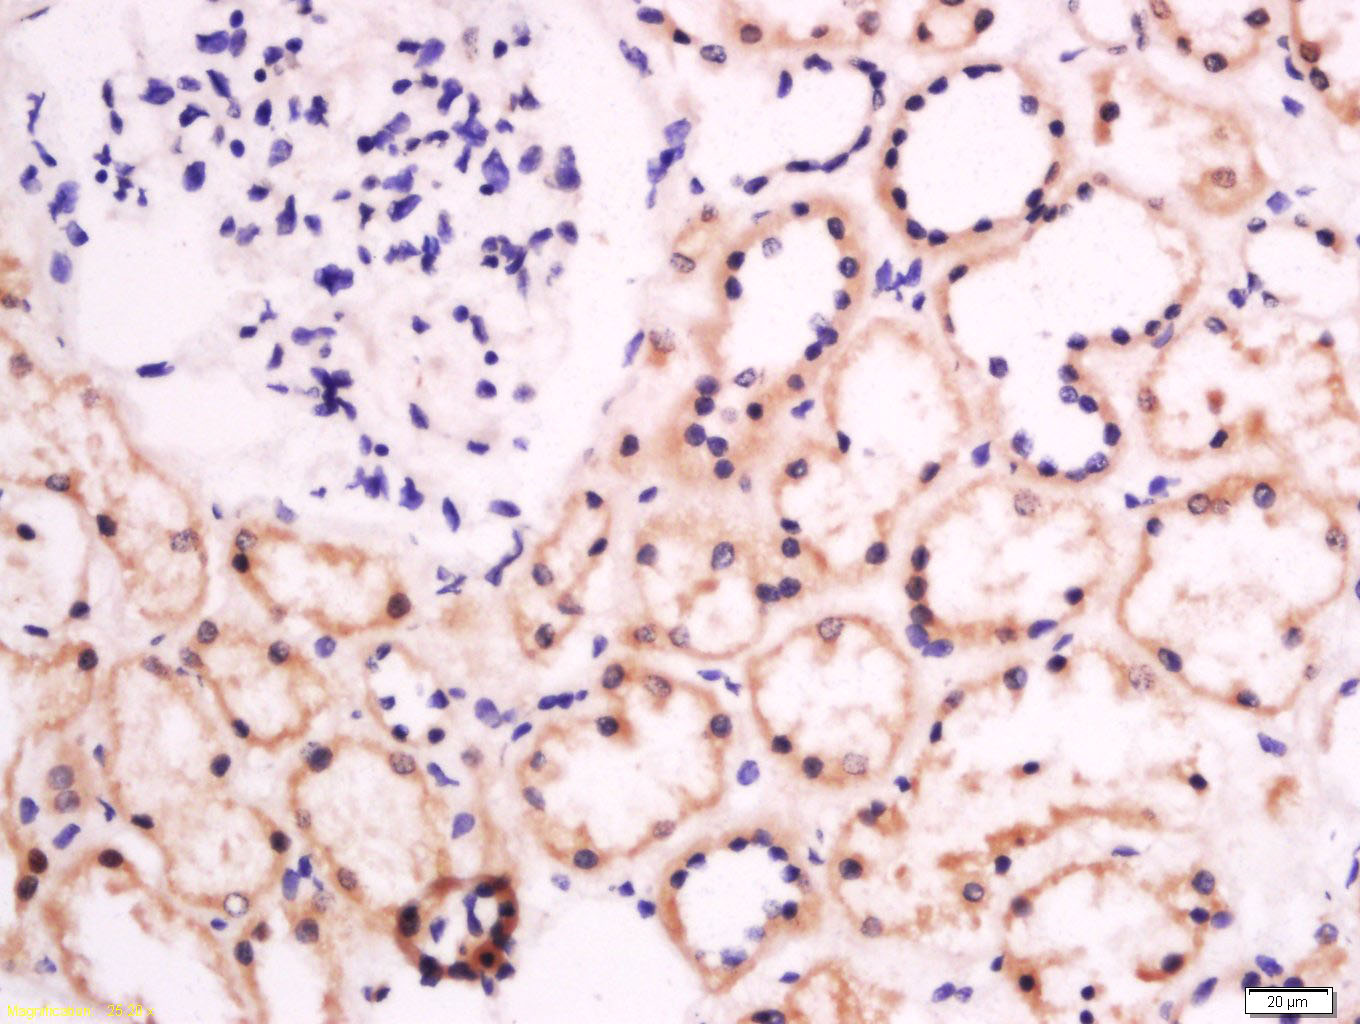
产品细节图片3

相关产品推荐更多 >
万千商家帮你免费找货
0 人在求购买到急需产品
- 详细信息
- 文献和实验
- 技术资料
- 应用范围:
产品信息以Bioss网站为准
- 规格:
50ul/100ul/200ul
| 规格: | 50ul | 产品价格: | ¥1180.0 |
|---|---|---|---|
| 规格: | 100ul | 产品价格: | ¥1980.0 |
| 规格: | 200ul | 产品价格: | ¥2800.0 |
| 产品编号 | bs-13251R |
| 英文名称 | Galactosylceramidase Rabbit pAb |
| 中文名称 | 半乳糖神经酰胺酶抗体 |
| 英文别名 | Gacy; Galactocerebrosidase; Galactocerebroside beta galactosidase; Galactosylceramide beta galactosidase; galactosylceraminidase; Galc; GALCERase; Twitcher; GALC_HUMAN. |
| 产品应用 | IHC-P=1:100-500, IHC-F=1:100-500, IF=1:100-500 Not yet tested in other applications. |
| 交叉反应 | Human, Mouse, Rat (Chicken, Dog, Pig, Cow, Horse, Rabbit, Sheep) |
| 抗体来源 | Rabbit |
| 免疫原 | KLH conjugated synthetic peptide derived from human G protein-regulated inducer of neurite outgrowth 2 |
| 亚型 | IgG |
| 性状 | Liquid |
| 纯化方法 | affinity purified by Protein A |
| 克隆类型 | Polyclonal |
| 理论分子量 | 73 kDa |
| 浓度 | 1mg/ml |
| 储存液 | 0.01M TBS (pH7.4) with 1% BSA, 0.02% Proclin300 and 50% Glycerol. |
| 研究领域 | Cardiovascular > Lipids / Lipoproteins > Lipid Metabolism > Hydrolysis Metabolism > Pathways and Processes > Metabolic signaling pathways > Lipid and lipoprotein metabolism > Hydrolysis Neuroscience > Neurology process > Neurodegenerative disease Signal Transduction > Metabolism > Lipid metabolism |
| 亚细胞定位 | Lysosomal. |
| 组织特异性 | Highest level of activity in testes compared to brain, kidney, placenta and liver. Can also be found in urine. |
| 相似性 | Belongs to the glycosyl hydrolase 59 family. |
| 功能 | Galactosylceramidase hydrolyzes the galactose ester bonds of galactosylceramide, galactosylsphingosine, lactosylceramide, and monogalactosyldiglyceride. It is an enzyme with very low activity responsible for the lysosomal catabolism of galactosylceramide, a major lipid in myelin, kidney and epithelial cells of small intestine and colon. It shows highest level of activity in testes compared to brain, kidney, placenta and liver. It can also be found in urine. Defects in Galactosylceramidase are the cause of globoid cell leukodystrophy (GLD); also known as Krabbe disease. This autosomal recessive disorder results in the insufficient catabolism of several galactolipids that are important in the production of normal myelin. Clinically, the most frequent form is the infantile form. Most patients (90%) present before six months of age with irritability, spasticity, arrest of motor and mental development, and bouts of temperature elevation without infection. This is followed by myoclonic jerks of arms and legs, oposthotonus, hypertonic fits, and mental regression, which progresses to a severe decerebrate condition with no voluntary movements and death from respiratory infections or cerebral hyperpyrexia before 2 years of age. However, a significant number of cases with later onset, presenting with unexplained blindness, weakness and/or progressive motor, and sensory neuropathy that can progress to severe mental incapacity and death, have been identified. |
| 保存条件 | Shipped at 4℃. Store at -20℃ for one year. Avoid repeated freeze/thaw cycles. |
| 注意事项 | This product as supplied is intended for research use only, not for use in human, therapeutic or diagnostic applications. |
| 背景资料 | GALC is a lysosomal enzyme that hydrolyzes galactose ester bonds in various galactolipids, including galactosylceramide, galactosylsphingosine, lactosylceramide and monogalactosyldiglyceride. Galactolipids contain glucose and/or galactose, and are found in the brain and other nerve tissue, especially the myelin sheath. Galactosylceramide is a major lipid in myelin, kidney, and epithelial cells of the small intestine and colon. Mutations in the GALC gene that compromise protein function correlate to Krabbe disease (globoid cell leukodystrophy, GLD). GLD is an autosomal recessive condition that affects approximately 1 in 150,000 infants and results in progressive destruction of the nervous system. The “twitcher” mouse is a model system for GLD; the genotype is a premature stop codon (W339X) in the galactosylceramidase (GALC) gene that abolishes enzymatic activity. Alternate transcriptional splice variants, encoding different isoforms, have been characterized. |
| 应用 | 推荐稀释比例 |
| {IHC-P} | {1:100-500} |
| {IHC-F} | {1:100-500} |
| {IF} | {1:100-500} |

Antigen retrieval: citrate buffer ( 0.01M, pH 6.0 ), Boiling bathing for 15min; Block endogenous peroxidase by 3% Hydrogen peroxide for 30min; Blocking buffer (normal goat serum,C-0005) at 37℃ for 20 min;
Incubation: Anti-GALC/Galactosylceramidase Polyclonal Antibody, Unconjugated(bs-13251R) 1:200, overnight at 4°C, followed by conjugation to the secondary antibody(SP-0023) and DAB(C-0010) staining

Antigen retrieval: citrate buffer ( 0.01M, pH 6.0 ), Boiling bathing for 15min; Block endogenous peroxidase by 3% Hydrogen peroxide for 30min; Blocking buffer (normal goat serum,C-0005) at 37℃ for 20 min;
Incubation: Anti-GALC/Galactosylceramidase Polyclonal Antibody, Unconjugated(bs-13251R) 1:200, overnight at 4°C, followed by conjugation to the secondary antibody(SP-0023) and DAB(C-0010) staining
Antigen retrieval: citrate buffer ( 0.01M, pH 6.0 ), Boiling bathing for 15min; Block endogenous peroxidase by 3% Hydrogen peroxide for 30min; Blocking buffer (normal goat serum,C-0005) at 37℃ for 20 min;
Incubation: Anti-GALC Polyclonal Antibody, Unconjugated(bs-13251R) 1:200, overnight at 4°C, followed by conjugation to the secondary antibody(SP-0023) and DAB(C-0010) staining

Antigen retrieval: citrate buffer ( 0.01M, pH 6.0 ), Boiling bathing for 15min; Block endogenous peroxidase by 3% Hydrogen peroxide for 30min; Blocking buffer (normal goat serum,C-0005) at 37℃ for 20 min;
Incubation: Anti-GALC Polyclonal Antibody, Unconjugated(bs-13251R) 1:500, overnight at 4°C, followed by conjugation to the secondary antibody(SP-0023) and DAB(C-0010) staining
风险提示:丁香通仅作为第三方平台,为商家信息发布提供平台空间。用户咨询产品时请注意保护个人信息及财产安全,合理判断,谨慎选购商品,商家和用户对交易行为负责。对于医疗器械类产品,请先查证核实企业经营资质和医疗器械产品注册证情况。
文献和实验[IF={{ 3.171 }}] {Yang-Yang Wang. et al. Nogo-A aggravates oxidative damage in oligodendrocytes. Neural Regen Res. 2021 Jan;16(1):179} {IF} {Rat}
= NAL), appears to form upon oxidative cyclization of the nonfluorescent 2:1 lysine-HNE Michael adduct-Schiff base cross-link (Scheme 1). Polyclonal antibody (PAb) to the NAL-HNE fluorophore was raised in rabbit and found to be highly specific
GE Healthcare Benzamidine Sepharose™ 6B is p-aminobenzamidine covalently attached to Sepharose 6B by the epoxy coupling method. p-Aminobenzamidine (PAB), is a synthetic inhibitor of trypsin-like serine protease. Trypsin and trypsin
Nucleic Acid Programmable Protein Arrays: Versatile Tools for Array‐Based Functional Protein Studies
.g., Sigma) 50 mg/ml bis‐sulfosuccinimdylsuberate (BS3 ;Pierce, cat. no. PI 21580) in dimethylsulfoxide (DMSO) 5 mg/ml
技术资料暂无技术资料 索取技术资料








